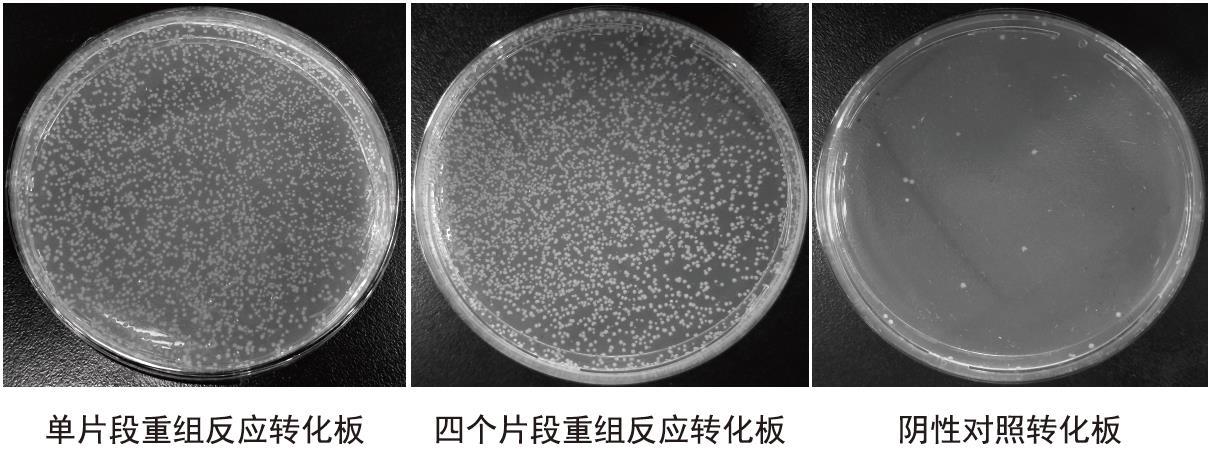
灵活多变的一体化超快速克隆试剂盒 ClonExpress U

相关产品推荐更多 >
万千商家帮你免费找货
0 人在求购买到急需产品
- 详细信息
- 询价记录
- 文献和实验
- 技术资料
- 保存条件:
- 20℃保存
- 保质期:
一年
- 英文名:
ClonExpress Ultra One Step Cloning Kit
- 库存:
充足
- 供应商:
南京诺唯赞生物科技有限公司
- 规格:
25 rxns/50 rxns
| 规格: | 25 rxns | 产品价格: | ¥800.0 |
|---|---|---|---|
| 规格: | 50 rxns | 产品价格: | ¥1300.0 |
ClonExpress Ultra One Step Cloning Kit
兼容单片段、多片段、入门克隆的一步法克隆试剂盒

快速克隆;高通量克隆;无缝克隆;DNA定点突变;双链DNA与载体组装

· 快速:5 - 15min快速重组
· 简单:一管式Mix,操作简便
· 高效:高效克隆50 bp~10 kb片段,阳性率>95%
· 兼容:单片段、多片段、入门克隆三合一
· 零背景:提供零背景、氨苄/卡那双抗性载体
· 提供在线引物设计:提供在线引物设计软件

1.高度简化的实验流程
通过PCR扩增,使插入片段5’和3’最末端分别带有和线性化载体两末端一致的序列(15 - 20 bp)。用2 × ClonExpress Mix,50℃反应5-15 min,进行重组。重组产物直接转化感受态细胞,平板上会形成数百个单克隆供阳性筛选。
2.优异的克隆效率
试剂盒能够高效克隆50 bp-10 kb片段,不同长度单片段50 bp、2 kb、4.5 kb、7.5 kb、10 kb;多片段:四个片段(3 kb)、三个片段(10 kb)、五个片段(3 kb)、五个片段(6 kb),纯化后分别与pCE-Zero vector进行同源重组,重组产物转化化学感受态细胞DH5α(Vazyme #C502),菌落数如下图所示。
试剂盒独特的非连接酶依赖体系,无载体自连,克隆阳性率高达95%以上。重组产物转化平板后,各挑取50个单克隆进行菌落PCR鉴定,不同长度插入片段阳性率如下图所示。

3.广泛的体系兼容性
试剂盒兼容1至5个片段同源重组,搭配Vazyme高保真酶,PCR产物可不经过纯化直接进行克隆。重组产物转化化学感受态细胞DH5α(Vazyme #C502),XL10(Vazyme #C503),Fast-T1(Vazyme #C505),得到较高克隆效率。
4.载体序列信息及测序方案
pCE-Zero vector载体,测序时使用通用测序引物(M13)即可。

本试剂盒作为新一代的重组克隆试剂盒,可快速、高效的将1 - 5个片段定向克隆至任意载体的任意位点。该试剂盒独特的非连接酶依赖体系,降低了载体自连背景,且无需考虑插入片段自身携带的酶切位点。操作简便快捷,50℃条件下仅需5 - 15 min即可完成重组反应。

|
组分 |
C115-01(25 rxns) |
C115-02(50 rxns) |
|
2 × ClonExpress Mix |
125 μl |
2 × 125 μl |
|
pCE-Zero vector,linearized (50 ng/μl) * |
25 μl |
50 μl |
|
500bp control insert (20 ng/μl) |
5 μl |
5 μl |
*双抗性载体:Amp+,Kan+

- 20℃保存。
C115
风险提示:丁香通仅作为第三方平台,为商家信息发布提供平台空间。用户咨询产品时请注意保护个人信息及财产安全,合理判断,谨慎选购商品,商家和用户对交易行为负责。对于医疗器械类产品,请先查证核实企业经营资质和医疗器械产品注册证情况。
- 作者
- 内容
- 询问日期
 文献和实验
文献和实验Cloning of Taq polymerase-amplified PCR products
out the gel slice containing the PCR product and melt it at 65°C in 2 volumes of 6 M NaI. 4) Add 1.5 volumes Binding Buffer (provided in the S.N.A.P. ™ MiniPrep Kit). 5) Load solution (no more than 1 ml at a time) from Step 3 onto a S
Raf 蛋白 Ras 结合结构域的简并进化库合成以及利用片段互补法快速筛选二氢叶酸还原酶的快速折叠且稳定的克隆
聚合酶(Fermentas)。 ( 3 ) 琼脂糖凝胶:agarose (Bioshop) Dark reader™ (Clare Chemical Research ) 和 GelstarTM ( Biowittaker Molecular Applications)。 ( 4 ) 凝胶纯化试剂盒:QIAEX™II 或 QIAquick™gelextractionkit ( Qiagen) 更好。 2.2 文库的克隆和纯化 ( 1 ) 质粒 PQE-32△F
 技术资料
技术资料需要更多技术资料 索取更多技术资料











